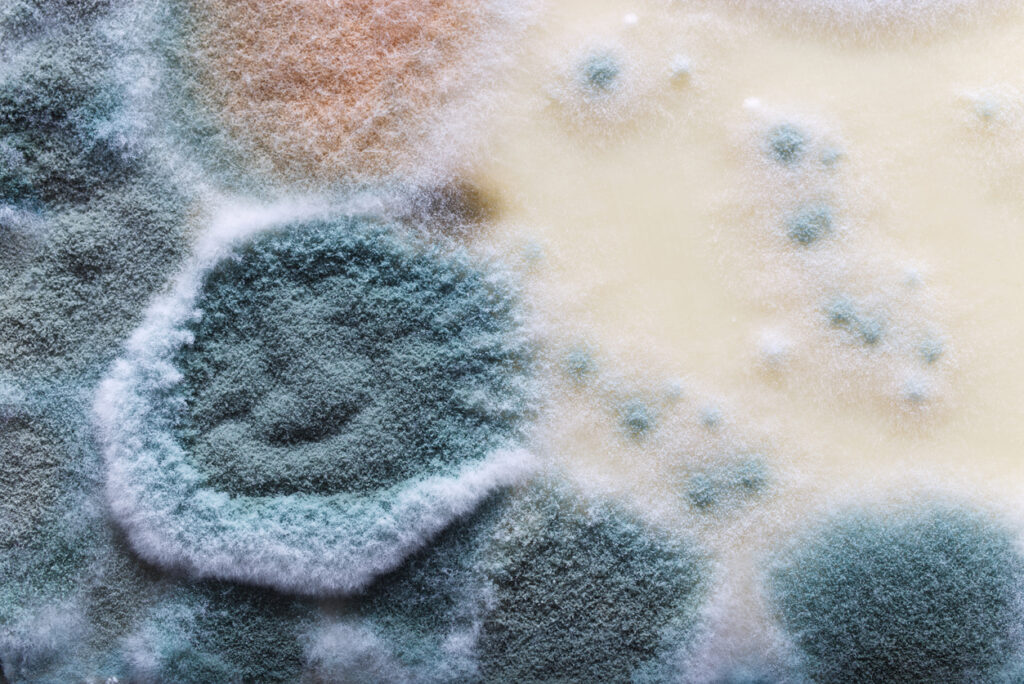
How Long Does it Take for Mold to Form

Apartment Mold Testing in Keller, TX
Apartment mold testing is a critical service for tenants, landlords, and property managers in Keller, TX who want to protect their health, property, and comply with legal responsibilities. Whether you are a tenant concerned about indoor air quality, a landlord preparing a unit for new occupants, or a property manager addressing resident complaints, understanding apartment mold testing in Keller, TX, is essential. Mold testing is essential for early detection to stop mold from spreading, and professional mold testing helps identify and address mold issues before they escalate.
Mold growth in apartments can cause significant stress for Keller residents and property managers alike. Because apartments share walls, plumbing, and ventilation systems, moisture problems can spread quickly between units if not identified early. That’s why apartment mold testing is an essential service for protecting indoor air quality and maintaining a healthy living environment.
At Mold Test DFW, we provide detailed mold inspection and testing services for apartments throughout Keller and the surrounding areas. Whether you are a tenant noticing unusual odors, a property manager addressing complaints, or a landlord preparing a unit for new occupants, professional apartment mold testing can help identify hidden issues and clarify the property’s condition.
Why Apartment Mold Testing Is Important in Keller, TX Apartments
Mold is a naturally occurring fungus found indoors and outdoors. Mold spores travel through the air and can settle on damp surfaces, where they begin to grow if moisture is present. Mold can quietly grow on many types of properties, causing damage before anyone realizes it’s there. Indoors, mold commonly develops when materials like drywall, wood, carpet, or insulation become wet due to leaks, humidity, or water damage. Mold infestation can occur when mold growth becomes widespread and problematic, posing health and structural risks.
Moisture is the primary factor that allows mold to grow inside buildings. When moisture accumulates, spores can quickly develop into mold colonies on organic building materials. Because mold spores are already present in the air everywhere, controlling moisture is the key to preventing mold growth. Allowing mold growth to persist can lead to significant structural damage and the destruction of personal belongings.
Apartment buildings often present additional challenges because they include shared plumbing systems, common HVAC ventilation, multiple occupants with different living habits, limited airflow in certain units, and higher humidity in bathrooms and kitchens.
When mold develops in one apartment, spores may circulate through shared air systems or structural spaces, potentially affecting neighboring units. This is why thorough inspection and apartment mold testing are important whenever mold is suspected, as detecting mold helps determine whether action is necessary.
Signs of Mold in an Apartment
Mold is not always visible, especially in apartments where it may grow behind walls or beneath flooring. However, there are several common warning signs that could indicate mold growth.
Musty or Earthy Odors
A persistent musty smell is one of the most common indicators of hidden mold. Mold releases compounds that produce a damp, earthy odor. If the smell persists even after cleaning, it may signal mold behind walls, inside cabinets, or within ventilation systems. A persistent musty odor may indicate a hidden mold issue that requires professional assessment.
Visible Discoloration
Mold can appear in various colors such as black, green, gray, white, or brown. It often appears as spots, streaks, or fuzzy patches on surfaces like walls, ceilings, baseboards, or around windows.
Even small patches can indicate a larger hidden issue.
Water Damage
Mold rarely develops without moisture. Signs of water damage may include yellow or brown stains on ceilings or walls, peeling paint or bubbling wallpaper, warped flooring or baseboards, damp drywall, or condensation on windows. These indicators suggest that moisture may be present inside the building materials.
Condensation and High Humidity
Excess humidity inside an apartment can create the ideal environment for mold growth. Bathrooms without proper ventilation, frequent cooking, or drying laundry indoors can all contribute to elevated humidity levels.
Allergy-Like Symptoms
Some individuals may experience symptoms when exposed to mold spores. These may include sneezing, runny nose, coughing, itchy or watery eyes, and skin irritation. While symptoms alone cannot confirm mold exposure, they can indicate that indoor air quality should be evaluated.
Areas in Apartments Where Mold Often Develops
Mold tends to grow in places where moisture accumulates and airflow is limited. During apartment mold testing in Keller TX, inspectors often focus on high-risk locations such as bathroom, kitchens, windows, exterior walls, HVAC systems and vents, laundry areas, and areas with appliances such as water heaters.
How Apartment Mold Testing Works
When mold is suspected in an apartment, professional apartment mold testing helps determine whether mold is present and what may be causing it. Testing for mold includes visual inspection for water damage, checks for musty odors, and professional air and surface sampling. Certified industrial hygienists conduct thorough mold assessments, ensuring a comprehensive evaluation.
Visual inspection for mold includes looking for black, green, or white spots and moisture sources like water stains. At Mold Test DFW, our knowledgeable professionals and certified inspectors follow a structured process to assess and inspect your Keller, TX property for potential mold problems.

Initial Inspection
The apartment mold testing process begins with a visual inspection of the apartment. Inspectors look for visible mold growth, water damage, condensation, and other indicators of moisture problems.
They may also ask questions about, past leaks or water damage, recent renovations or repairs, musty odors or indoor air concerns, and health symptoms experienced by occupants. Understanding the building’s history can help identify the potential source of the problem.
Moisture Detection
Moisture meters and thermal imaging tools may be used to detect hidden dampness inside walls, ceilings, or floors. These tools help locate moisture that is not visible on the surface.
Finding the moisture source is critical because mold cannot grow without water.
Air Sampling
Air samples may be collected to measure the concentration of mold spores inside the apartment compared to outdoor air levels. These samples help determine whether elevated mold levels exist indoors.
Air sampling can be especially useful when mold is suspected but not visible. During mold remediation, air scrubbers and HEPA vacuums are often used to capture microscopic mold spores and prevent their spread throughout the apartment.
Surface Sampling
Inspectors may collect samples directly from surfaces using methods such as swabs, tape lifts, or bulk samples. These samples can help identify the type of mold present.
Laboratory Analysis
Samples are sent to an independent laboratory for analysis. The lab determines the types of mold present and provides a report that helps guide next steps.
Detailed Report
After testing is complete, clients receive a comprehensive report that includes, inspection findings, sample results, identified moisture sources, and recommendations for remediation or prevention. This information helps property owners or tenants make informed decisions about addressing mold issues.
When to Schedule an Apartment Mold Test
There are several situations when professional apartment mold testing is recommended for apartments.
Persistent Odors
If a musty smell continues despite cleaning and ventilation, hidden mold may be present.
Water Damage
Leaks from plumbing, roofs, or neighboring units can allow mold to grow inside walls or flooring.
Recurring Mold
If mold continues to return after cleaning, the underlying moisture problem may not have been resolved.
Property Transactions
Apartment mold inspections are often conducted during property purchases or lease transitions to ensure the space is safe for occupancy.
Health Concerns
If residents experience unexplained allergy-like symptoms that improve when they leave the apartment, indoor air quality testing may be helpful.
What Happens After Mold Is Found
If mold is identified during testing, the next step is determining the best way to resolve the issue. Mold remediation involves removing mold-infested materials and treating affected areas to prevent recurrence. Mold Test DFW can recommend certified technicians to provide effective mold remediation services in Keller, TX.
The most important factor is addressing the moisture source. Without eliminating the underlying water problem, mold will likely return.
Common solutions may include repairing plumbing leaks, improving ventilation, reducing humidity levels, replacing damaged materials, and cleaning affected surfaces.
Removal, cleanup, and restoration are essential parts of the remediation process. Highly trained professionals use specialized equipment and protocols to remove mold safely and ensure safety during remediation. The use of antimicrobial spray is important to disinfect and prevent the recurrence of microbial growth after cleaning.
Professional mold remediation and remediation services may be recommended if mold growth is extensive or located in difficult-to-access areas. The restoration process includes thorough removal of contaminated materials, cleanup, and restoring the property to its pre-damage condition. If mold covers over 25 square feet, a licensed Texas mold assessor is required for professional assessment. By law, the same company cannot conduct both mold assessment and remediation in Texas.
After remediation, follow-up testing may be performed to confirm that mold levels have returned to normal.
Tenant and Landlord Responsibilities in Texas
Understanding legal responsibilities is crucial for both tenants and landlords when dealing with mold in Keller, Texas apartments:
Tenants should notify landlords in writing about mold issues, ideally using certified mail for proof.
Landlords typically have seven days to begin repairs after receiving proper written notice from tenants.
Landlords in Texas must address underlying water leaks that cause mold but are not required to conduct mold testing.
Tenants are responsible for maintaining proper ventilation and reporting leaks to prevent mold growth.
If mold covers over 25 square feet, a licensed Texas mold assessor is required for professional assessment.
By following these guidelines, both parties can help ensure a safe and healthy living environment and remain compliant with Texas law.
Why Choose Mold Test DFW for Apartment Mold Testing Keller TX
Apartment mold issues can be complex because they often involve multiple units, shared ventilation, and hidden moisture sources. Professional apartment mold testing helps ensure that the problem is accurately identified and addressed. Mold Test DFW tailors its services to the unique challenges faced by Keller residents, providing solutions that address local conditions in Texas.
At Mold Test DFW, our licensed inspectors provide thorough mold testing and inspection services designed to identify mold problems and determine their root causes. Our team uses advanced equipment and proven inspection methods to deliver reliable results for apartments throughout Keller and the greater Dallas–Fort Worth area. Texas mold assessors must be licensed by the Texas Department of Licensing and Regulation (TDLR), ensuring that our services meet state standards.
We understand the unique challenges of Keller apartment buildings and work with tenants, landlords, and property managers to deliver clear reports and actionable recommendations. When we perform apartment mold testing, our commitment to customers includes prioritizing their health and property, as well as protecting employees’ health and safety during every step of the process.

Schedule Apartment Mold Testing in Keller TX Today
If you suspect mold in your apartment or want to ensure your unit is safe and healthy, professional testing is the best way to gain peace of mind. Apartment mold testing in Keller is essential for early detection to stop mold from spreading, and professional mold testing helps identify and address mold issues before they escalate.
Mold Test DFW provides expert mold inspection and testing services for apartments in Keller TX and throughout the Dallas–Fort Worth metroplex. Our team delivers detailed evaluations, accurate testing, and practical recommendations to help protect your indoor environment.
Contact Mold Test DFW today to schedule professional apartment mold testing and take the first step toward making your Keller, TX living space cleaner and healthier.
